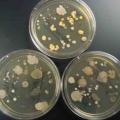
touch-plates-far-sil.jpg

Φονικά τραύματα στο κρανίο ενός συγγενούς του ανθρώπου, το οποίο χρονολογείται προ 430.000 ετών και ανακαλύφθηκε σ
Το DNA των μικροβίων που ζουν στο ανθρώπινο σώμα μπορεί να χρησιμοποιηθεί για να ταυτοποιηθεί ένας άνθρωπος, κάτι που...
Οι άνθρωποι με αδύναμη χειραψία αντιμετωπίζουν αυξημένο κίνδυνο για έμφραγμα, για εγκεφαλικό και για άλλα προβλήματα υγεία
Στις εποχικές διακυμάνσεις που παρουσιάζει η λειτουργικότητα των γονιδίων, και άρα του ανοσοποιητικού συσ
Ίσως πρέπει να αναθεωρήσετε τη σκέψη να αγοράσετε εκείνο το θαυμάσιο εξοχικό σπίτι πάνω στο κύμα.
Ο Βέλγος φυσικός Φρανσουά Ανγκλέρ (Francois Englert), ο οποίος τιμήθηκε το 2013 με το Νόμπελ Φυσικής, μαζί με τον Βρετανό Πίτερ...
Γάλλοι επιστήμονες ισχυρίζονται ότι κατάφεραν για πρώτη φορά στον κόσμο να δημιουργήσουν στο εργαστήριό τους ανθρώπινα σπε
Ακούγεται απίστευτο, αλλά είναι πέρα για πέρα αληθινό: Με τη βοήθεια της τελευταίας λέξης της τεχνολογίας στην τρι
Το μη επανδρωμένο διαστημόπλοιο Progress, διαλύθηκε εισερχόμενο στην ατμόσφαιρα. Το φλεγόμενο τέλος του σκάφους, που ήταν
Ένας μεγάλος αριθμός πλανητών ενδέχεται επομένως να έχει αποθηκευμένους όγκους νερού που θα μπορούσαν να συγκριθούν με εκε
Ύστερα από δύο χρόνια επισκευών και αναβαθμίσεων και αφού τον περασμένο Απρίλιο κυκλοφόρησε ξανά η πρώτη ακτίνα σωματιδίων